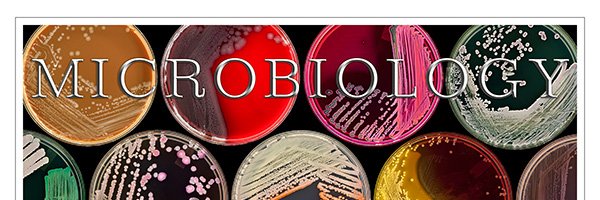
SimnerLab banner

SimnerLab retweetledi

Important leadership news at Pattern:
Carey-Ann Burnham, our chief clinical officer since 2022, is now CEO! Founder Nick Arab transitions to CTO, focusing on advancing our single-cell microbiology tech.
More details: pattern.bio/pattern-biosci…

English